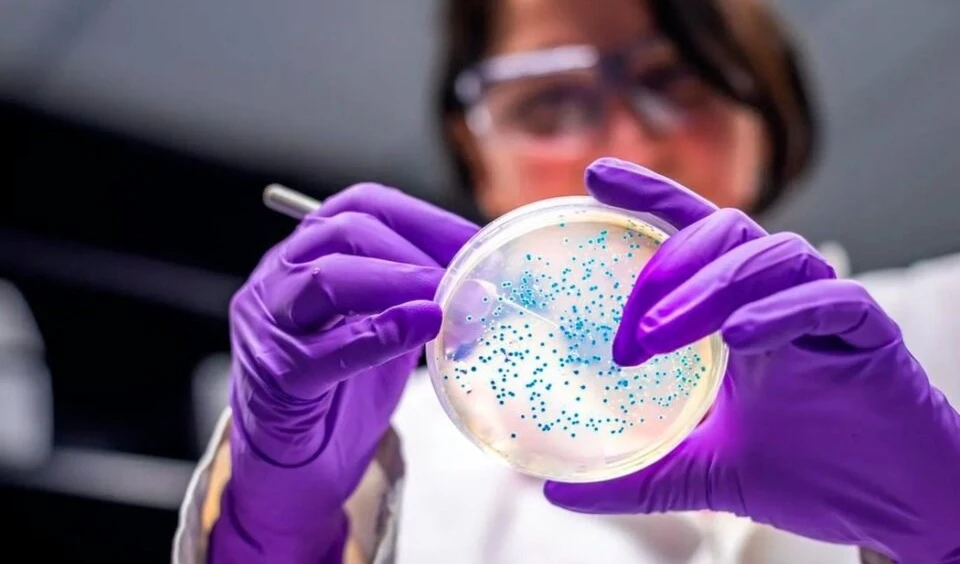
Descubren por qué algunas bacterias muertas regresan a la vida. Foto: AFP.

Bacterias de la piel producen moléculas para tratar el acné
Un estudio experimental produjo una proteína a partir de un tipo de bacteria de la piel.
-

Bacterias de la piel producen moléculas para tratar el acné. Foto: Pixabay.
Una investigación internacional editó de forma eficiente la Cutibacterium acnés, un tipo de bacteria cutánea, para producir y secretar la molécula terapéutica adecuada para tratar los síntomas del acné.
Este hallazgo abre la puerta a ampliar la ingeniería de microorganismos a la hora de solucionar alteraciones y otras enfermedades mediante terapias.
Los resultados del estudio publicados en Nature Biotechnology mostraron la edición del genoma para producir la proteína NGAL, conocida por ser un mediador contra esa afectación.
Para su edición, el equipo de expertos dirigido por la Universidad Pompeu Fabra centró su labor en mejorar el suministro de la célula y estabilidad.
Además, tuvo en cuenta las medidas reguladoras desarrollando una estrategia de biocontención para evitar el uso de elementos preocupantes.
“Podemos ofrecer circuitos para crear microbios inteligentes para aplicaciones relacionadas con la detección cutánea o la modulación inmunológica", señaló el director del proyecto, Marc Güell.
El acné es una afección cutánea común causada por la obstrucción o inflamación de los folículos pilosebáceos.
Su aparición muestra diferentes formas, desde puntos blancos o puntos negros hasta pústulas y nódulos que aparecen, principalmente, en la cara, la frente, el pecho, la parte superior de la espalda y los hombros.
Aunque es más frecuente entre los adolescentes y jóvenes, afecta a personas de todas las edades.